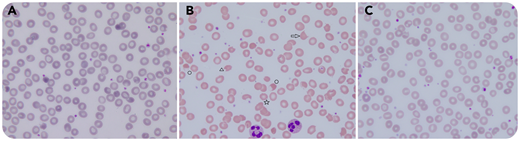
An 80-year-old man was hospitalized with severe acute respiratory syndrome coronavirus 2 (SARS-CoV-2) pneumonia. Because of worsening clinical and radiological lung involvement, the protease inhibitors lopinavir/ritonavir were prescribed. Eight days later, schistocytes appeared on the patient’s blood smear (panel B). His laboratory results indicated the following: hemoglobin, 7 g/dL; reticulocytes, 19 × 103/µL; platelets, 462 × 103/µL; and leukocytes, 12.3 × 103/µL. Lactate dehydrogenase was elevated (607 U/L) but all other hemolysis parameters and creatinine were normal. Blood smear testing (panels A-C: original magnification ×1000, hematoxylin and eosin stain) showed marked anisopoikilocytosis (panel B) with echinocytes (☆), bite cells (△), keratocytes (⇨), and ghost cells (○). These changes were not present the day before lopinavir/ritonavir administration (panel A) and disappeared 5 days after treatment cessation (panel C).

An 80-year-old man was hospitalized with severe acute respiratory syndrome coronavirus 2 (SARS-CoV-2) pneumonia. Because of worsening clinical and radiological lung involvement, the protease inhibitors lopinavir/ritonavir were prescribed. Eight days later, schistocytes appeared on the patient’s blood smear (panel B). His laboratory results indicated the following: hemoglobin, 7 g/dL; reticulocytes, 19 × 103/µL; platelets, 462 × 103/µL; and leukocytes, 12.3 × 103/µL. Lactate dehydrogenase was elevated (607 U/L) but all other hemolysis parameters and creatinine were normal. Blood smear testing (panels A-C: original magnification ×1000, hematoxylin and eosin stain) showed marked anisopoikilocytosis (panel B) with echinocytes (☆), bite cells (△), keratocytes (⇨), and ghost cells (○). These changes were not present the day before lopinavir/ritonavir administration (panel A) and disappeared 5 days after treatment cessation (panel C).
Based on the absence of thrombocytopenia and hemolysis, the variety of the observed red blood cell (RBC) alterations, and the timing between their appearance and medication exposure, we concluded that the RBC morphological alterations were most likely induced by lopinavir and/or ritonavir. Both have been described as agents that induce eryptosis, an RBC-programmed death that permits clearance of defective and injured erythrocytes by phagocytosis. Eryptosis is induced by several triggers, such as oxidative stress, energy depletion, toxins (ie, heavy metals), and some drugs. It is characterized by increased cytosolic free calcium concentration and subsequent surface phosphatidylserine exposure. Morphological alteration ensues with volume reduction, membrane vesiculation, and blebbing. Eventually, altered RBCs are cleared by phagocytosis in the reticuloendothelial system.
An 80-year-old man was hospitalized with severe acute respiratory syndrome coronavirus 2 (SARS-CoV-2) pneumonia. Because of worsening clinical and radiological lung involvement, the protease inhibitors lopinavir/ritonavir were prescribed. Eight days later, schistocytes appeared on the patient’s blood smear (panel B). His laboratory results indicated the following: hemoglobin, 7 g/dL; reticulocytes, 19 × 103/µL; platelets, 462 × 103/µL; and leukocytes, 12.3 × 103/µL. Lactate dehydrogenase was elevated (607 U/L) but all other hemolysis parameters and creatinine were normal. Blood smear testing (panels A-C: original magnification ×1000, hematoxylin and eosin stain) showed marked anisopoikilocytosis (panel B) with echinocytes (☆), bite cells (△), keratocytes (⇨), and ghost cells (○). These changes were not present the day before lopinavir/ritonavir administration (panel A) and disappeared 5 days after treatment cessation (panel C).
Based on the absence of thrombocytopenia and hemolysis, the variety of the observed red blood cell (RBC) alterations, and the timing between their appearance and medication exposure, we concluded that the RBC morphological alterations were most likely induced by lopinavir and/or ritonavir. Both have been described as agents that induce eryptosis, an RBC-programmed death that permits clearance of defective and injured erythrocytes by phagocytosis. Eryptosis is induced by several triggers, such as oxidative stress, energy depletion, toxins (ie, heavy metals), and some drugs. It is characterized by increased cytosolic free calcium concentration and subsequent surface phosphatidylserine exposure. Morphological alteration ensues with volume reduction, membrane vesiculation, and blebbing. Eventually, altered RBCs are cleared by phagocytosis in the reticuloendothelial system.
For additional images, visit the ASH Image Bank, a reference and teaching tool that is continually updated with new atlas and case study images. For more information, visit http://imagebank.hematology.org.